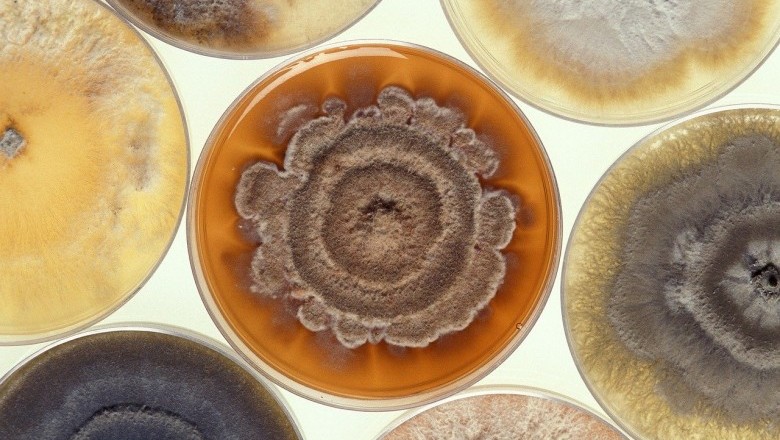
Black Mold Is A Dangerous Fungus

Black Mold Is A Dangerous Fungus
Mold is a fungus development , which starts with a microscopic spore. It can easily spread in damp environment like food and wood. It can be beneficial; for example, the antibiotic penicillin is a mold. Usually you can find mold everywhere but the mold at workplace and dwelling can become a largest difficulty.
As I mentioned above mold grows anywhere that dark and dank conditions that let them to grow . When you try to kill them, they take to the air, scattering themselves with no forethought to the damage they can cause . They are simply trying to live on.
Spores can be spreaded over air and there is is chance to inhale them and more over it can be absorbed through skin .And, because some people are more susceptible than others, one person may turn out to be harmed by exposure to mold in the dwelling, another person sharing the same surroundings is essentially unaffected.
People who are very much sensitive with immune system deficiencies due to disease, chemotherapy are more vulnerable to intense illness .
Everybody on the earth is more worried about health issues caused by mold. In particular, stachybotrys chartarum, which you may have heard about as "toxic black mold", has been blamed for causing fitness troubles. It is greenish-black, slimy, and can expand in homes with water damage
Many paople affecetd with a number of ailments because of black mold and mildew. Common effects from molds such as stachybotrys atra, penecillium, cladosporium and quite a few strains of aspergillius, are asthma, pneumonitis, upper respiratory troubles, sinusitis, dry cough, skin rashes, stomach upset, headaches, disorientation and bloody noses. Numerous other species of mold and mildew are also deadly, and many mycotoxins are well-known carcinogens. Severe exposures can lead to internal bleeding, kidney and liver failure and pulmonary emphysema. Such health risks due to the presence of mold in a dwelling are a serious concern to occupants, and can pose impending liability for owners of rental properties.
All the residential properties are widley getting tainted because of mold. Although mankind has been informed for thousands of years that mold thrives in damp environment, only in recent times have we begun to understand how dramatically its existence can influence us. You are in trouble if you believe that mold exists only in old buildings.
Black mold is very much dangerous to the health of humanbeing as is is a unsafe fungus which leads to toxic symdrome . Block mold was answerable for the deaths of infants in last couple of years. Taking protective steps are very important if you notice any symbols fo mold in your home . There are solutions!
You can have healthy environment inside the home by maintaning good quality of air in side. Clean air is obtained by prevent black mold and mildew from rising everyplace in your dwelling.
Are you still having trouble hunting for a organic mold and mildew cleaner to kill black mold? Find out which black mold cleaner can kill mold and shield it from coming back.